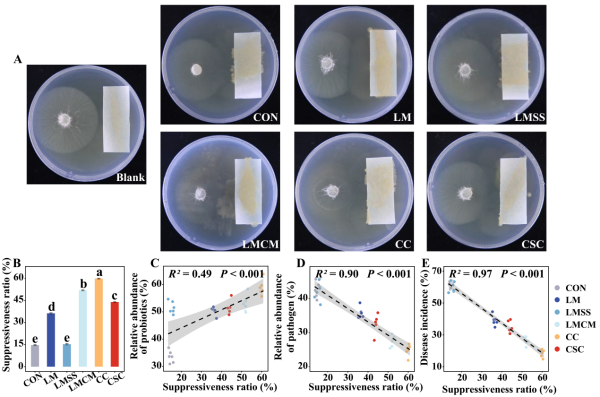

東北地理所在土壤改良劑緩解大豆連作障礙的發(fā)生機(jī)制研究取得新進(jìn)展
黑龍江是我國(guó)大豆的主產(chǎn)區(qū),但近年來,大豆連作現(xiàn)象日益嚴(yán)重,導(dǎo)致了土壤酸化、養(yǎng)分失衡和土傳病害頻發(fā)等連作障礙問題,嚴(yán)重制約了大豆生產(chǎn)的可持續(xù)發(fā)展。土壤改良劑被廣泛認(rèn)為是緩解連作障礙的有效農(nóng)藝措施,但其如何通過重塑土壤微生物組來實(shí)現(xiàn)病害抑制和產(chǎn)量提升的機(jī)制尚不明確。中國(guó)科學(xué)院東北地理與農(nóng)業(yè)生態(tài)研究所農(nóng)田分子生態(tài)學(xué)科組通過田間定位試驗(yàn)與室內(nèi)共培養(yǎng)實(shí)驗(yàn)相結(jié)合,系統(tǒng)解析了土壤改良劑消減大豆連作障礙的微生物調(diào)控機(jī)制。
基于海倫水土保持監(jiān)測(cè)研究站的田間定位試驗(yàn)平臺(tái),設(shè)置了對(duì)照(CON)、石灰(LM)、石灰秸稈配施(LMSS)、石灰牛糞配施(LMCM)、2%粗甲殼素(CC)及硅鈣鉀鎂肥(CSC)6種改良處理,系統(tǒng)評(píng)估了其對(duì)土壤性質(zhì)、微生物群落、大豆根腐病發(fā)病率及產(chǎn)量的影響。結(jié)果顯示,改良劑能有效降低大豆根腐病發(fā)病率和提高大豆產(chǎn)量,其中CC抑病和增產(chǎn)效果最大,根腐病發(fā)病率降低70%,產(chǎn)量提高30%以上。土壤改良劑顯著富集了具有抑病和促生功能的潛在有益物種,如Pantoea、Bacillus、Humicola、 Tausonia和Mortierella,同時(shí)減少了潛在病原菌(圖1)。體外共培養(yǎng)實(shí)驗(yàn)進(jìn)一步驗(yàn)證,改良土壤的根際細(xì)菌懸液明顯抑制了病原菌菌絲的生長(zhǎng),且該抑病能力與富集的有益菌豐度呈顯著正相關(guān)(圖2)。土壤改良劑,特別是CC處理誘導(dǎo)了最高的微生物抗性,證實(shí)改良劑能夠通過誘導(dǎo)健康的微生物區(qū)系來緩解連作障礙(圖3)。本研究明確了“改良劑-微生物抗性-病害抑制-產(chǎn)量提升”的級(jí)聯(lián)調(diào)控路徑,為維持土壤健康和促進(jìn)作物生產(chǎn)提供了理論依據(jù)。
相關(guān)成果發(fā)表在國(guó)際期刊《Field Crops Research》上。東北地理所已畢業(yè)博士生樊艷麗為論文的第一作者,劉俊杰研究員為通訊作者。研究得到國(guó)家自然科學(xué)基金(42177105,U23A6001)、國(guó)家重點(diǎn)研發(fā)計(jì)劃(2022YFD1500202)和中國(guó)科學(xué)院國(guó)際合作項(xiàng)目(131323KYSB20210004)的共同資助。

圖1不同改良劑施用下土壤微生物群落抗性及潛在有益菌和植物病原菌的相對(duì)豐度
圖2不同土壤改良劑施用下根際土壤細(xì)菌懸液對(duì)植物病原菌的抑制效果

圖3改良劑介導(dǎo)的土壤性質(zhì)和微生物群落特征與抑病能力及大豆產(chǎn)量的互作關(guān)系
論文信息如下:
Fan Y L,Liu J J*,Liu Z X,Gu H D,Hu X J,Yu Z H,Li Y S,Jin J,Liu X B,Wang G H. Soil amendments alleviate continuous cropping obstacles in soybean by enhancing microbial resistance. Field Crops Research,2026,337: 110261.
論文鏈接:
https://doi.org/10.1016/j.fcr.2025.110261
附件下載:
吉公網(wǎng)安備22017302000214號(hào)